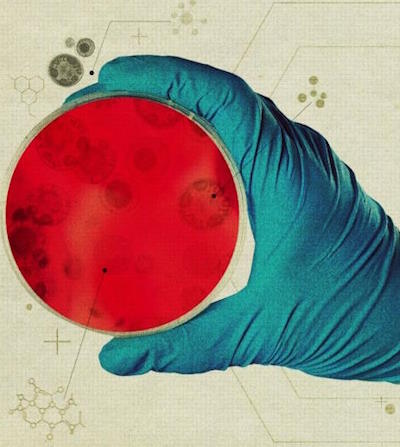
Что такое зеркальная жизнь? Учёные бьют тревогу Что такое зеркальная жизнь? Учёные бьют тревогу

Шнобелевская премия
Шнобелевская премия - это рок-н-ролл в музыке науки. Ig-Nobel.ru
Шнобелевская премия (Ig Nobel Prize) — пародия на престижную международную награду — Нобелевскую премию. Десять Шнобелевских премий вручаются в сентябре, перед тем, когда называются лауреаты Нобелевской премии.
Присуждение Шнобелевской премии, возможно, является самым главным событием в научном календаре. Nature.
| Карл Крушельницкий (Karl Kruszelnicki) | просто нужно быть хорошим программистом | аномальное восприятие тела | Динамика жидкости при мочеиспускании |
 |  |  |  |
| Загрязняет ли операционную медсестра тихо пукая? | Взлом банковских PIN-кодов с помощью игры «Мастермайнд» | Восприятие «отсутствующего пальца» у здоровых людей | выбросы жидкости в природе |
Награда, которую ученые Гарварда присуждают за самые одиозные и бессмысленные научные открытия и изобретения.
Премия, вносящая новый смысл в само понятие юмор! Boston Globe.
Каждая Шнобелевская
Премия смешна или не смешна по своему. И нечему тут смеяться. К сожалению не все научные работы, как и прочая деятельность homo, получили заслуженное признание, хохот или презрение. Но у них еще есть шанс. Пытливый ум найдет не мало поучительного в разделах
Пресса (труды опубликованы в разных местах) и
Анналы (опубликованы на improbable.com, самом настоящем шнобелевском сайте).
| когда размер имеет значение | отчет по зеркальным бактериям | Эми Уайнхаус (Amy Winehouse) 1983-2011 | Застрявшее ножевое лезвие — впечатляющая травма |
 | |  |  |
| Площадь поверхности женской груди и кожная чувствительность | Что такое зеркальная жизнь? Учёные бьют тревогу | Цена славы? Риск смертности среди известных певцов | Лечение застрявшего ножевого лезвия |
Потрясающий юмор и невероятный полет воображения! Publisher Weekly. Предмет Шнобелевского отличия может быть хорошим и плохим, важным и незначительным, ценным и бесполезным.
Название Ig Nobel Prize представляет собой игру слов. На английском языке
Нобелевская премия называется Nobel Prize, схожее со словом «noble» прилагательное «ignoble» означает «позорный». На русский язык название премии чаще всего переводится как «Антинобелевская премия», «Игнобелевская премия» или «Шнобелевская премия». Известно еще, что шнобель - это большой и красивый нос.
| М А Р С | Иза ван Римсдейк (Iza van Riemsdijk) | Никогда не экономь, особенно, когда денег совсем нет | Самый важный удар в гольфе — следующий |
 |  |  |  |
| Может ли болгарский йогурт улучшить неутомимость астронавтов? | Мухобойки – Коллекция Изы ван Римсдейк | Выгодные возможности совершения покупок | Механика вылета мяча в гольфе |
Истерический хохот читателю гарантирован, не разбудите соседей! Washington Post. Шнобелевская премия так же важна, как Нобелевская премия, но во многих случаях гораздо важшее. Премией награждаются люди, совершившие нечто невероятно бессмысленное - иногда достойное восхищения.
| Каарина Кайкконен (Kaarina Kaikkonen) | популярная игровая платформа Roblox | Андреа Скотти (Andrea Scotti) | ноги лежащей в машине женщины |
 |  |  |  |
| Каарина Кайкконен — современная финская художница | Оценка эффективности видеоигры Roblox в улучшении восприятия собственного тела | Как приготовить идеальную пасту — использовать ускорители частиц и реакторы | Автомобиль как средство повышения сексуальной активности |
Каждый из обладателей премии может с полным основанием считаться уникумом. Некоторые годами мечтают получить эту премию, но им не везет. Другим она сваливается на голову совершенно неожиданно.
Премии вручаются за достижения, которые заставляют сначала
засмеяться, а потом —
задуматься (first make people laugh, and then make them think). Премия учреждена Марком Абрахамсом и юмористическим журналом «Анналы невероятных исследований».
| прямые волосы с сильным блеском | австралийская сорока (Australian Magpie) | The Lancet предупреждает: Журналы-хищники | Данные секвенирования зубов 13 солдат |
 |  |  |  |
| Восприятие женского возраста, здоровья и привлекательности по блеску волос | Половые и возрастные различия у австралийских сорок, пострадавших от авиаудара | Журналы-хищники: что мы можем сделать, чтобы защитить их добычу? | Паратиф и возвратный тиф в 1812 году разгромили армию Наполеона |
Заслужить Шнобелевские почести не так-то просто, шансы вообще не получить премию очень велики. Шнобелевским лауреатам вручают премию, которая может быть выполнена в виде медали из фольги или купюры в 100 триллионов зимбабвийских долларов (меняется от случая к случаю), а также сертификат подписанный тремя лауреатами Нобелевской премии.
| 370 Malaysia Airlines, Boeing 777-200ER | Оран О’Рейли (Oran O’Reilly) | В Северной Ирландии | Максудул Шадат Акаш (Maksudul Shadat Akash) |
 |  |  |  |
| Cамоубийство с использованием гражданского воздушного судна | ИССЛЕДОВАНИЕ КОСТЮМОВ СЕКС-РАБОТНИЦ В КИНО | Травмы, полученные от пластиковых дубинок | Мечеть как тело: грудь, фаллос и архитектура молитвы |
Шнобелевские премии присуждаются за такие достижения, которые невозможно воспроизвести или же нет смысла это делать. Шнобелевскую премию вручают в Гарварде, США. Больше нигде и никогда. Награду лауреатам вручают самые настоящие нобелевские лауреаты.
Ключем ко всякой науке является вопросительный знак. Оноре де Бальзак
| Эрик Тринкаус (Erik Trinkaus)
| Фабрицио Ольмеда (F. Olmeda)
| Франсиско Санчес (Francisco Sanchez)
| богатый бережёт ноги, а бедный - обувь
|
 |  |  |  |
| Характер травм среди неандертальцев | Шнобелевская премия 2025 по физике | Авиационная Шнобелевская премия 2025 | Запах обуви - возможность перепроектировать полку для обуви |
такими важными моментами всенепременно следует поделиться в соцсетях